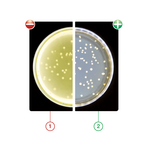
0

Colony Counters
Automating colony counting is one strong productivity improvement. Our technology allows for the counting of regular and spiral plates and has the capacity to read bar codes for maximum traceability and process flow improvement.
Back to category pageManual Colony Counter Accurate view and work comfort New
When it comes to colony counting, the main requirement is an accurate and contrasted view of the colonies counted. Scan® 100 is well equipped for that purpose, with a LED lighting system with Dark-Field technology.
1. Standard neon lighting: agar and the colonies become yellowish and as a result: contrast is imperfect, colonies are difficult to count.
2. Dark Field technology: colonies are perfectly lit on a dark background. As a result: the lighting is accurate and the contrast is optimal, colonies are easy to count.
The touch of your pen on each colony increments the displayed count, and the the integrated USB port allows export of the results to the software of your choice. Scan 100 is a simple solution combining for highly accurate colony counts and ergonomy.

Specs
Hardware

Automatic Colony Counter Accurate view and work comfort New
The automatic colony counter is the perfect tool for routine bacterial enumeration and reliable result storage. From numerous media, colonies are detected in less than one second. Brightness, contrast and sensitivity are automatically optimized by the software. The counted colonies and images of the media are sent to a powerful data management system.
It saves hours of cumbersome manual counting and standardize the results between users. The system stores settings for preset media (PCA/TSA, MRS, VRBL, TBX, TSC, Baird Parker, GVPC, L.Mono, YM …) and counts according to these settings instead to according to individual operator.
Three models are offered, according to laboratory needs. The Scan 350 reads regular Petri dishes and Spiral plated Petri dishes.
For Chromogenic Petri dishes, the Scan 500 adds detection of up to 7 colors on the same Petri dish to the Scan 300 counting capabilities. It also allows the reading of antibiograms, reading up to 8 antibiotic sensitivities in 1 click, and the results are compared to the built-in antibiotic database.
Finally, the Scan 1200 features a High resolution camera, for zoom up to x28, detection of smaller colonies and count from media as Petrifilms, RIDA COUNT/Sanita-kun, Compact Dry and filtration membrane.
Download Brochure
Comparative
![]() |
![]() |
![]() |
|
|---|---|---|---|
| Scan 300 | Scan 500 | Scan 1200 | |
| Budget-friendly | Effiency with more media to count on | High resolution with full range of media to count on | |
| CCD color camera | Zoom x7 | Zoom x7 | Zoom x28 |
| Camera resolution | 640x480 | 640x480 | 1280x960 |
| Minimum size of detected colony | 0.1 mm | 0.1 mm | 0.05 mm |
| Detects and count up to 7 colors on the same Petri dish | |||
| Fully automatic lighting | |||
| Petri dishes | |||
| Spiral plates | |||
| Chromogenic petri dishes | |||
| Antibiograms | |||
| Petrifilms (with optional adaptor) | |||
| RIDA COUNT/Sanita-kun (with optional adaptor) | |||
| Compact Dry (with optional adaptor) | |||
| Filtration membrane (with optional adaptor) | |||
| Technical Sheet | Download | Download | Download |


















